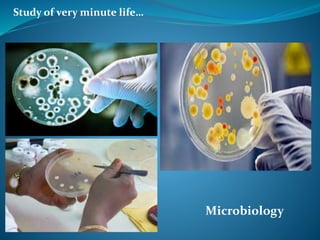
Study of very minute life…
Microbiology

The document lists one-word substitutes for various locations, objects, and characteristics, detailing terms such as 'aviary' for a place where birds are kept and 'stable' for a place for horses. It also includes definitions for roles, like 'charwoman' for a cleaning woman and 'juggler' for an entertainer using hand tricks. Additionally, it covers academic studies like 'botany' for plant studies and 'zoology' for animal studies.